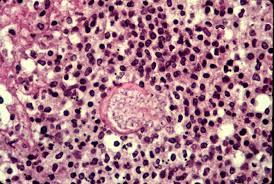

What are the proteins involved in and function of gap junctions?
§ Proteins - Connexins
§ Function - Intercellular communication
o What are the proteins involved in and function of tight junctions?
§ Proteins - claudins, occludin
§ Function - paracellular barrier
o What are the proteins involved in and function of adherins junctions?
§ Proteins - cadherins
§ Function - cellular anchor
o What are the proteins involved in and function of desmosomes?
§ Proteins - cadherins (e.g. desmoglein)
§ Function - cellular anchor
What are the proteins involved in and function of hemidesmosomes?
§ Proteins - integrins
§ Function - cellular anchor
Describe the geographic locations associated with histoplasmosis, blastomycosis, coccidiomycosis, and paracoccidiomycosis
Histo - Mississippi and Ohio river valleys (central US)
Blasto - Eastern and central US
Coccidio - Southwestern US
Para-coccidio - Latin America
Describe the histologic appearance of histoplasmosis
Smaller than RBCs
Macrophage filled with ovoid cells

Describe histologic appearance of blastomycosis
Round yeast with single broad based bud
Same size are RBCs

Describe the histologic appearance of coccidiomycosis
Spherule filled with endospores
Much larger than RBCs
Describe histology of para-coccidiomycosis
Budding yeast with “captain’s wheel formation”
Much larger than RBCs

Describe the mechanism behind glucagon as a treatment for beta blocker toxicity
Enzyme used to create ribose-5-phosphate in HMP shunt
Transketolase
Causes and basic premise behind phenylketonurie (PKU)
Tyrosine deficiency
Due to:
o Deficiency in phenylalanine hydroxylase, or
o Deficiency in tetrahydrobiopterin cofactor (BH4)

Basic premise behind maple syrup urine disease
THINK: I Love Vermont maple syrup from branched maple trees
§ Branches - blocked degradation of branched amino acids
§ I - Isoleucine
§ Love - leucine
§ Vermont - Valine
Presentation of maple syrup urine disease
CNS defects, intellectual disability, and death
Basic premise behind Alkaptonuria
Inability to degrade tyrosine due to defect of homogentisate oxidase

Presentation of phenylketonuria
Causes of homocysteinuria
o Cystathionine synthase deficiency
o Decreased affinity of cystathionine synthase for B6
o Methionine synthase deficiency

Presentation of homocysteinuria
o Homocysteine in urine
o Marfanoid habitus
o Ocular changes (downward and inward lens subluxation – vs. Marfan which is upward)
o CV effects (thrombosis and atherosclerosis)
o Kyphosis
o Intellectual disability
Cause of cystinuria
Defect in proximal convoluted tubule of the kidney in the COLA transporter (Cysteine, Ornithine, Lysine, Arginine)
Defect prevents reabsorption of COLA amino acids
Presentation of cystinuria
Excess cysteine in urine can lead to hexagonal cysteine stones
What is CREST syndrome?
· Calcinosis / anti-centromere antibody
· Raynoud
· Esophageal dysmotility
· Sclerodactyly (tightening of skin with loss of wrinkles)
· Telangiectasias
Cause and presentation of Hyper-IgE Syndrome (aka Job)
o Deficiency in IFN-y lead to impaired neutrophil recruitment
o Presentation - FATED
§ F – coarse Facies
§ A – Abscesses
§ T – retained primary Teeth
§ E – increased IgE (all other immunoglobulins are normal)
§ D – dermatologic problems (eczema)
Infliximab